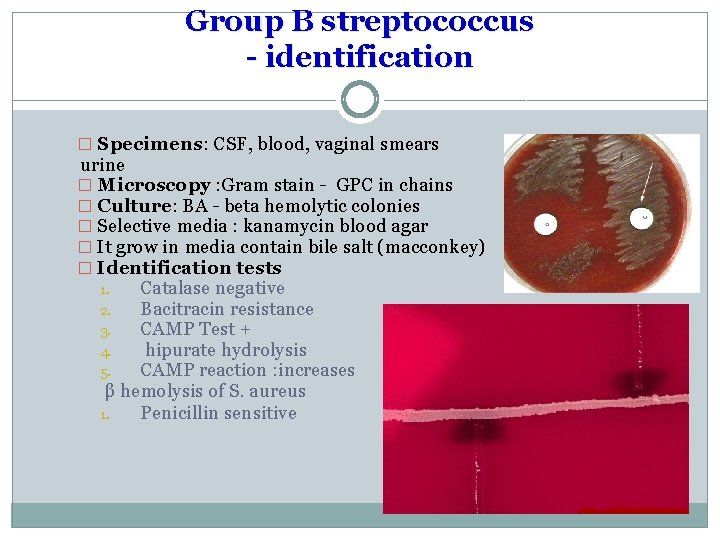
Group B streptococcus - identification � Specimens: CSF, blood, vaginal smears urine � Microscopy

Genus Streptococcus Dr Rayan Abdelwahid Genus Streptococcus Members

Genus Streptococcus Dr. Rayan Abdelwahid

Genus Streptococcus �Members of this genus are widely distributed in environment �some are non pathogenic and could be a part of normal flora present in pharynx, mouth, intestine and female genital tract. �Others are pathogenic from simple to complex Membrane of this group are non motile, non spore forming, some are capsulated.

Culture characters �Growth occur only in enriched media, majority are �facultative i. e. can grow under aerobic or anaerobic conditions �grow at 37 c but is aided by 5 -10% co 2. Few are obligatory �anaerobic e. g peptostreptococcus. � Nutritionally streptococci are fastidious m. o. and only grow on enriched media for example blood agar, chocolate agar and can’t grow on simple media like nutrient agar, it arranged in chains or in pairs.

Classification of Streptococcus �Specific criteria are used in classification of Streptococci 1. Type of growth on blood agar medium. 2. Serologic specificity. 3. Biochemical and physiological factors. 4. Capsular polysaccharide.

1. Type of growth on blood agar 1. β-hemolytic Streptococci: clear zones of hemolysis around the colonies. 2. α – hemolytic Streptococci : partial or incomplete hemolysis around the colony ex. Viridans streptococci , Streptococcus pneumoniae. 3. γ type of hemolysis ( Non hemolytic) streptococci : no change on surface of blood agar. Group β streptococci is the most important group of streptococci

Antigenic structure of hemolytic streptococci 1. Carbohydrate antigen C antigen �Its group specific cell wall antigen which is carbohydrate in nature and it’s located in the cell wall of many streptococci �Lancefield grouping �On basic of this antigen β-hemolytic Streptococci are divided in to groups from A-U except I and J �A B C D E F G H K L M N O P Q R S T U (Lancefield groups)

Antigen extract �This antigen can be extracted from bacterial cells by one of the three methods 1. by treatment with hot Hcl. 2. by enzymatic lysis of cell (with trypsin or pepsin) 3. by autoclaving

Medical important spp �Group A streptococci (streptococcus pyogenes ) Is the most important human pathogen it can cause pharyngitis , tonsillitis �Group B streptococci (Streptococcus agalaectiae ) Normal flora of female genital tract and can cause neonatal sepsis and meningitis. �Group D streptococci include: - Enterococci Non Enterococci

Antigenic structure of hemolytic streptococci � 2. M- protein � It’s associated with virulence of group A streptococci. It’s type specific and on basis of this antigen, group A streptococci are subdivided into 60 types � , it help the bacteria to resist phagocytosis with group A streptococci � streptococci having different types of M protein(80 type of M proteins) 3. T substance � This antigen has no relation to the virulence of streptococci. � T-substance is acid labile and heat labile and it’s obtained from streptococci by proteolytic digestion. � It’s used in epidemiological studies as “typing marker. ” 4. Nucleoprotein : � Antigens associated with streptococcal cell body

Toxins and enzymes of group A streptococci (Extracellular product) 1. Hemolysins (streptolysins) 2. Streptokinase (fibrinolysin) 3. Streptodornase (DNase) 4. Hyaluronidase (spreading factor) 5. Erythrogenic toxin

extracelluar products that are antigenic are � Haemolycine: it have 2 type � 1. Streptolysin O � Streptolysin O is a protein that is hemolytic ally active in the reduced state but rapidly inactivated in the presence of oxygen its antigenic and combines quantitively with antistreptolysin O (ASO) � this antibody blocks hemolysis by Streptolysin O. � Streptolysin O +RBCs = hemolysis � Streptolysin O+ASO+ RBCs = no hemolysis � The ASO titer can be applied in the diagnosis of streptococcal infections. � Serum titer >200 I. U. is considered abnormal

Disease caused by streptococcus pyogene �Can be divided into two groups : 1. Suppurative infection (pus forming). 2. Non suppurative sequelae.

Suppurative infection include � A) Strep. Pharyngitis most common in infants and small children , � there is extension to the surrounding tissue causing otitis media , mastoiditis, meningitis. The tonsils are usually enlarged with enlarged tender cervical lymph nodes. � B) Strep. Infection can involve URT causing pneumonia which most commonly occur after viral infection. � C) Streptococcus pyoderma. � D) Erysipelas: which is spreading infection of the skin or mucous membrane usually seen on the face. � E) Surgical wound infection. � F) purpural sepsis: streptococcus enter the uterus after delivery causing purpural fever. � G) Scarlet fever. � H) Streptococcus toxic shock syndrome

Non suppurative infection � Post Streptococcus disease � 1. Acute rheumatic fever: Certain strain of group A hemolytic streptococci with cell membrane antigen, this cross react with human heart muscles producing AB which react with human heart muscles and valves, it is a hypersensitivity response � and it caused by � M protein cross-reacts heart myosin autoimmunity � Cell wall antigens poorly digested in vivo persist indefinitely 2. Acute glomerulonephritis : After skin infection or after pharyngitis by two to three weeks, certain GAHS type 2, 4, 12, 49, 59, 61 known as nephritogenic strain causing Nephritis initiated by (antigen- antibody) complex on the glomerular basement membrane

Isolation and identification �β hemolytic colonies bacitracin inhibits growth �β hemolytic colonies group A antigen


Biochemical Identification � Susceptibility tests � Specimens: throat swab, pus, blood � Microscopy : Gram stain - GPC in chains � Culture: BA - beta hemolytic colonies � Crystal violet blood agar- as selective � media � Identification tests Catalase Negative Bacitracin sensitive Bacitracin (0. 04 units) or “A” disk Identifies Group A streptococci Penicillin sensitive PYR TEST ASO titre / DNAase B test

Beta hemolytic Group B (Streptococcus agalaectiae) �Normal flora in lower GIT, female genital tract �Pathogenicity Neonatal meningitis Puerperal sepsis Pneumonia
Group B streptococcus - identification � Specimens: CSF, blood, vaginal smears urine � Microscopy : Gram stain - GPC in chains � Culture: BA - beta hemolytic colonies � Selective media : kanamycin blood agar � It grow in media contain bile salt (macconkey) � Identification tests 1. Catalase negative 2. Bacitracin resistance 3. CAMP Test + 4. hipurate hydrolysis 5. CAMP reaction : increases β hemolysis of S. aureus 1. Penicillin sensitive

Group D Streptococcus �Enterococcus – 2 important species �E. fecalis �E. faecium �Normal flora in GIT, lower genital tract �Nosocomial / opportunistic pathogen �UTI, wound infection, endocarditis �Resistance to cephalosporin, even vancomycin

Group D streptococcus �Growth on bile esculin agar black precipitate � 6. 5% saline � grow enterococci �no growth non-enterococci Litmus milk media: causing white and clott reaction.

Alpha hemolytic streptococci Streptococcus pneumoniae �Virulence factor – capsule �Pathogenicity Otitis media, sinusitis - commonest Pneumonia Meningitis Other suppurative lesions - Pericarditis, conjunctivitis, arthritis, peritonitis �Vaccine available for prevention – polyvalent polysaccharide vaccine

Lab diagnosis �Specimen: CSF, blood, sputum, pus, swabs �Microscopy: Gram stain – GPC in pairs, capsulated, lancet shape. �Culture BA/ CA – alpha hemolytic colonies �Identification tests 1. 2. 3. 4. Catalase –ve Quellung test Optochin sensitive Bile solubility sensitive

Alpha hemolytic streptococci Streptococcus viridans �Normally present on teeth, throat, colon & female genital tract �Pathogenicity – Endocarditis & Dental caries

Viridans streptococcus diverse species �oral �dental caries � α hemolytic and negative for other tests �non-groupable. �includes S. mutans occasional endocarditis after tooth extraction

Differences between Viridans Gp & Pneumococci Point Morphology Quellung test Pneumococci Capsulated, lanceolate, diplococci + Viridans Gp Oval or rounded in chains - Colonies Dome shaped Draughtsman Dome shaped Growth in liquid Uniform turbidity Granular turbidity with powdery deposits Bile solubility + - Inulin fermentation + - Optochin sensitivity + - Intraperitoneal inoculation in mice Fatal Infection Non-pathogenic


Overview of the Medically Important Gram Positive Cocci Family, Genus, species Characteristics Clinical manifestations Staphylococcaceae Cocci in cluster; catalase-positive Staphylococcus aureus Coagulase +ve, yellow-pigmented colonies Pyogenic infections, toxicoses S. epidermidis Coagulase -ve, whitish colonies, normal flora Foreign body infections Streptococcaceae Cocci in chains and in pairs, catalasenegative Streptococcus pyogenes Cocci in chains, Lancefield group A, β - hemolysis Tonsillitis, scarlet fever, skin infections S. pneumoniae Diplococci, α-hemolysis Pneumonia, otitis media, sinusitis S. agalactiae Chain-forming cocci, group antigen B, βhemolysis Meningitis/sepsis in neonates S. viridans Cocci in chains, α-hemolysis Endocarditis, dental caries Enterococcaceae In chains & pairs, α, β, or γ-hemolysis, group antigen D, catalase -ve Flora of intestines of humans and animals Enterococcus faecalis Aesculin-positive, growth in 6. 5% Na. Cl, Opportunistic infections
- Slides: 28